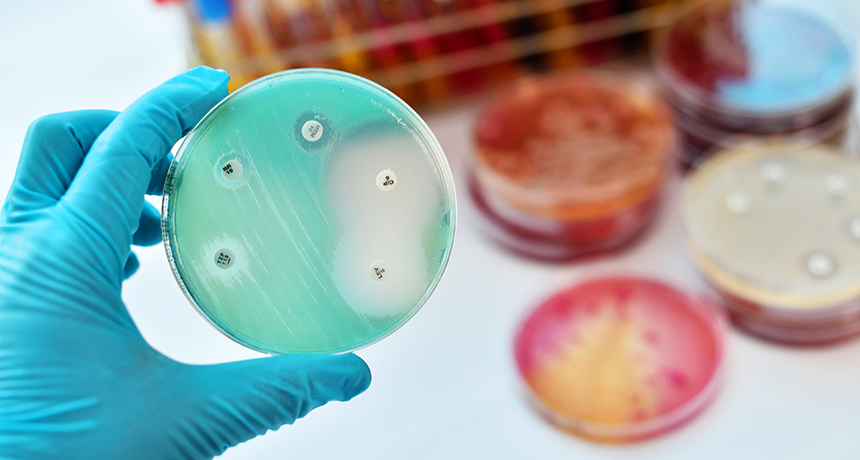
860_bacteria_eat_antibiotics.png

Nom, nom! These bacteria eat antibiotics for lunch
That drug munching may seem scary, but it could be harnessed to clean up antibiotic pollution
Some bacteria can use antibiotic drugs as fuel. Now, scientists have figured out how they do it.
jarun011/iStockphoto
Share this:
- Share via email (Opens in new window) Email
- Share on Facebook (Opens in new window) Facebook
- Share on X (Opens in new window) X
- Share on Pinterest (Opens in new window) Pinterest
- Share on Reddit (Opens in new window) Reddit
- Share to Google Classroom (Opens in new window) Google Classroom
- Print (Opens in new window) Print
Bacteria have a lot of ways to avoid the drugs people use to kill them. Some pump the drugs away. Others shield their vulnerable parts with protective coatings. Some bacteria even chew up drugs. And if they’re chewing, why not also eat them? A new study shows how some microbes do just that: They turn the drugs meant to kill them into a bacterial buffet.
Scientists might one day harness these findings to help rid the environment of polluting drugs.
Some of the first antibiotics — chemicals used to kill bacteria — were found in organisms living in soil. Bacteria, mold and other microbes constantly duke it out for space, food and other resources. Some have evolved chemicals to kill each other. People simply took those molecules and adapted them for medicine and other uses.
But in this kill-or-be-killed world, one bacterium’s weapon can trigger another’s new defense. And some bacteria living in the soil indeed have learned not only to break down antibiotics, but also to eat them.
Such bugs can use parts of the germ-killing drug as fuel, explains Daria Van Tyne at Harvard University in Cambridge, Mass. As a microbiologist she studies microbes.
All of this “makes sense,” Van Tyne says, “given that a lot of antibiotics come from the soil.” Until now, she points out, scientists did not know “exactly how the eating worked.”
To catch a drug eater
Gautam Dantas is a microbiologist at Washington University in St. Louis, Mo. He and his colleagues set out to discover how bacteria could safely nosh on antibiotics. First, they had to find some germs that knew the trick. To do that, they needed dirt. “My father-in-law and mother-in-law live in Minnesota. They sent us some soil,” he says. “We [also] got some in Pennsylvania and went hiking in Massachusetts.”
The scientists set up their soil samples in petri dishes — shallow dishes used to grow bacteria. Then they gave the soil microbes nothing to eat but antibiotics, such as penicillin. Afterward, they waited to see if any bacteria grew. Some did. The researchers then separated these bugs out, gave them more penicillin and let them grow some more.

“It was a tedious process,” Dantas says.
Though some bacteria can grow on antibiotics, they don’t much like it. “It’s not their preferred food,” he says. Bacteria usually feed on sugars or amino acids (the building blocks of proteins). When fed only antibiotics, the microbes grow at only one-half to one-third the rate they would when fed their usual diet.
After working with many, many petri dishes of germs, Dantas and his group were left with four types of bacteria that could survive dining on antibiotics. They now looked at the genes — cellular instructions — within these bacteria. They also looked at what chemicals these microbes produced. The scientists were hunting for a shared set of instructions that would let a bacterium chop up and eat a penicillin molecule.
They didn’t know whether all four bacteria would use the same drug-digesting strategy. “But if they were all doing it the same way,” Dantas says, “the same pathway [should] come up.”
And it did.
How to eat a lion … or an antibiotic
Penicillin belongs to a group of antibiotics called the beta-lactams. The name comes from a chemical structure in the middle of the molecule called a beta-lactam ring. This ring has three carbon atoms and one nitrogen atom. The rest of the antibiotic hangs off this ring in all directions. And bacteria need three major steps to snack on penicillin.

The beta-lactam ring is the most dangerous part of the antibiotic. This ring allows the antibiotic to pop into the cell wall of a bacterium. It then stops the wall from holding the cell together. Fluids now leak out of the bacterium causing the cell to die.
The first step in dismantling an antibiotic is smashing its beta-lactam ring. It does this with an enzyme, a molecule that speeds up a chemical process. This enzyme, called beta-lactamase, chews open the ring. Now the antibiotic can no longer do its job.
Now it’s time to eat. But even with its beta-lactam ring busted open, the antibiotic is too big for a bacterium to eat whole. The drug must be cut down to size.
“Say you want to chop a lion in half,” Dantas says. If you cut it in the middle, between the front and back legs, you get two halves. “But they’re not equal halves,” he notes. “You’ve got the back end and the front end. It gives you two options: You can eat the head or the tail.”
For a bacterium trying to break down an antibiotic (instead of a lion), the second step is to use an enzyme called amidase. That breaks the molecule in two, leaving a front half and a back half.
The final step is to chew up the pieces. Dantas and his team pinpointed a group of 15 enzymes that other scientists had seen before. Those 15 enzymes did the trick. “They’re really good at eating the tail half of the ‘lion,’” he says. The enzymes reduce the “tail” of this drug to parts that the cell can use.
The scientists wanted to prove that the whole process was needed for bacteria to use antibiotics as food. So Dantas’ group took the genes for making the essential enzymes and stuck them in a different bacterium. This one belonged to a different species. They used E. coli, a germ that is popular in labs. E. coli normally die when faced with large amounts of antibiotics. But after being provided the new genes, the E. coli could eat up the drug.
Dantas and his colleagues published their findings April 30 in the journal Nature Chemical Biology.
Eating antibacterial trash
It might seem like bad news that soil microbes can eat the drugs designed to kill them. But Dantas actually sees it as an opportunity.
“A problem with antibiotics is that we tend to overuse them,” he notes. And the more people who are treated, the more wastes they excrete. Those excreted drugs leave toilets as part of the wastes flowing into sewers. They also may flow into streams from cows and other livestock that had been treated with drugs. Once in the environment, people need some way to break those drugs down, Dantas explains. And the newfound bacterial process might point to one possible solution.
“It’s interesting to think about using these bacteria to try and degrade the antibiotics that humans are putting into the environment,” says Van Tyne. But, she warns, scientists would have to be very careful. Bacteria love to swap genes with each other. Introducing a modified bacterium into the environment could end in disaster, she worries. How? Some dangerous neighboring microbe might pick up the genes needed to help it chew up the drugs meant to kill it.
What’s more, this bacterial pathway has evolved to tackle only one class of antibiotics in soil. It might be useless against related drugs made in a lab, Van Tyne says.
Dantas agrees that it’s important to be careful. It might be possible, however, to use the enzymes alone, he says, rather than putting them into some bacterium. Releasing something that could eat antibiotic pollution has a lot of potential. But there are risks to consider,” he says, such as “whether it should be done.”







